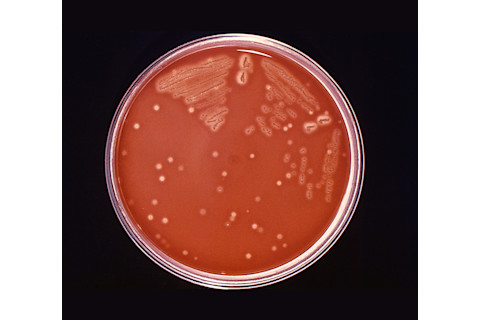
strep-colonies.jpg

卡拉身材修长,皮肤黝黑,留着一头长长的棕色秀发。她的笑容像夏日阳光一样温暖。但是,她那右眼!本应雪白的地方——我病人的巩膜——即眼球虹膜附近的坚韧纤维组织,却闪烁着霓虹红。
而且,卡拉的外表还有些不对劲。尽管她四肢纤细,但脸却浮肿圆润。
对于任何受过医学训练的人来说,证据不言而喻。在与她发炎的眼睛斗争的同时,这位 28 岁的时装设计师服用了大量的强的松。现在,她的身体出现了服用强效类固醇的典型迹象,包括“满月脸”、颈部后方的脂肪堆积以及血压升高。无论这些药物对她有多大帮助,都正在对她造成伤害。更糟糕的是,她的眼睛仍然在跳痛。
尽管如此,卡拉花了两小时在拥挤的南加州高速公路上,不是为了抱怨自己的容貌或疼痛。她预约我,是因为我的一位长期同事——一位著名的眼科医生——担心卡拉的副作用。
更重要的是,他担心真正的诊断被忽略了。
对我这个领域里的医生来说,这样的挑战简直就是阿加莎·克里斯蒂的“猫薄荷”。
几天前,他的电子邮件总结了问题。“卡拉患上了严重的巩膜炎,”他写道,“目前被当作自身免疫性疾病治疗。问题是,她的类风湿检查结果呈阴性,而且她的症状是在旅行后开始的。我知道西欧算不上什么奇特的地方,但当卡拉提到漂流、乡村徒步和昆虫叮咬时,我想她最好还是去看传染病专家。”
对我这个领域里的医生来说,这样的挑战简直就是阿加莎·克里斯蒂的“猫薄荷”。因此,现在我扮演了赫尔克里·波洛的角色,下一步就是运用我的“小小灰色脑细胞”。
临床经验有所帮助。第一步,在仔细考虑了同事的电子邮件后,我回忆起我职业生涯中见过的十几个病人。引发他们慢性眼部炎症的感染,从肺结核、梅毒到吸入性真菌病,比如山谷热。
另一方面,卡拉患上这些疾病的可能性有多大?我不得不承认,可能性不高。会不会是布鲁氏菌或沙门氏菌潜伏在未巴氏消毒的奶酪或未煮熟的肉类中,而它们才是引发她眼部“地狱之火”的导火索?或者,我沉思着,我应该寻找一种由媒介传播的罪魁祸首。从四月到十月,欧洲高阿尔卑斯山林里潜伏着蜱传播的脑炎,而奇ungunya——一种源自非洲的蚊子传播的病毒——已经在意大利东北部出现。
A 组链球菌细菌在培养皿中生长。 | CDC/Richard R. Facklam
最后,还有钩端螺旋体病,这是一种由老鼠、狗和其他动物通过在淡水湖泊和溪流中或附近排尿传播的感染。人类通过吸入或直接接触受污染的水而感染卷曲的钩端螺旋体细菌,会 suffer 多种免疫疾病。
哦,该死。我知道我是在徒劳地挣扎。更多的病史等于更多的线索,我决定。我显然需要更多的病史。
“那么,跟我说说去年夏天吧,”在对她长途跋涉的高速公路表示同情后,我问道,“你是一个人去的吗?你去了哪里?你做了什么?”
卡拉详述细节时,我一边写笔记。不,她说,她不是一个人旅行的。她和她最好的朋友以及一群冒险者一起游览了欧洲三周。在意大利、奥地利和莱茵河谷的乡村地区,他们徒步旅行,进行漂流,在多虫的湖边悠闲地喝酒,甚至喂养农场动物。
至于生病?“我们都感冒过,”卡拉回忆说,“你知道的——流鼻涕、鼻塞、咳嗽。”她停顿了一下,考虑着时间线。“但直到我们飞回家的那天,我和我的室友都得了非常严重的喉咙痛和淋巴结肿大。”
哇。这是个消息。“多告诉我一些,”我说。
“嗯,我朋友看了她的家庭医生,服用了抗生素。但当我去了急诊诊所时,我的喉咙拭子检查是阴性的,我自己也好了。直到一周后。那时我开始发高烧,身上出现斑点状皮疹。然后我退烧了,皮疹也消退了,我又好了个把星期,直到我的关节开始疼痛,我的膝盖肿了起来。”
“最后,”卡拉总结道,“我的右眼变红了,从那时起就一直红着。我需要给你发照片吗?”她善意地补充道。
我麻木地点了点头。我当然想看她的照片集。但我仍然被一个挥之不去想法所困扰。
“现在已经过去六个月了……而你一次抗生素都没吃过?”
“没错,”卡拉回答。
我麻木地点了点头。我当然想看她的照片集。但我仍然被一个挥之不去想法所困扰。
我想,在这个对滥用抗生素感到反感的时代,这听起来可能有些奇怪,但有些临床情况即使是“盲目治疗”也需要抗生素。所以,是的,我很快就决定了:我会排除我清单上所有奇怪的诊断。但现在我最怀疑的是 A 组链球菌,这是儿童和成人最常见——且可治疗——的引起喉咙痛的细菌。
即使卡拉六个月前在一家商店诊所的检测结果呈阴性,A 组链球菌也因其引起关节、心脏瓣膜和其他组织器官继发性炎症而臭名昭著,不再次寻找它将是愚蠢的。
我发誓——一旦我们的实验室拿到了卡拉的血清——就会开始给我的新病人服用抗生素。在她饱受折磨的六个月后,我仍然希望它们能缓解她的眼部炎症,并减少她对类固醇和其他免疫抑制剂的长期依赖。
事实也大致如此。卡拉最终服用了两种不同的抗生素,尽管她的喉咙培养结果仍然呈阴性,但抗体检测后来证明她最近感染了 A 组链球菌。此外,她的抗生素起到了神奇的作用。治疗一个月后,她的眼科医生再次写信,但这次是令人振奋的消息。“当我看到卡拉时,她的巩膜炎明显好转。她仍然有一些扩张的大血管……但这在长期的巩膜炎发作后很常见。眼睛不再疼痛或触痛。”
他还深入研究了医学文献,并在法国找到了一份病例报告,描述了一位与卡拉极其相似的患者。这位中年女性在患上严重的 A 组链球菌喉咙感染后,也遭受了巩膜炎。而且,就像卡拉一样,她的眼部问题在接受类固醇和青霉素治疗后消失了。
“卡拉的脸怎么了?”你可能想知道。慢慢地,当她逐渐减量到极低的泼尼松剂量后,她的脸恢复了正常轮廓。卡拉不再像嘴里塞满了坚果和种子的花栗鼠,她的血压也恢复正常了。不久前,她甚至通过了机动车驾驶执照部门的视力测试。最后,重复检测她的 A 组链球菌抗体水平大幅下降。
“我很高兴我又找回了我自己!”卡拉在我们第一次见面四个月后,在电话里告诉我。“几周后,我将是我表弟婚礼的伴娘。”
当然,卡拉还没有完全脱离危险。她仍在密切观察中。她目前还每周接受一种非甾体抗炎注射。考虑到她所经历的一切,她的医生们一致认为:我们需要彻底扑灭她眼部炎症的最后一点残余火苗。















